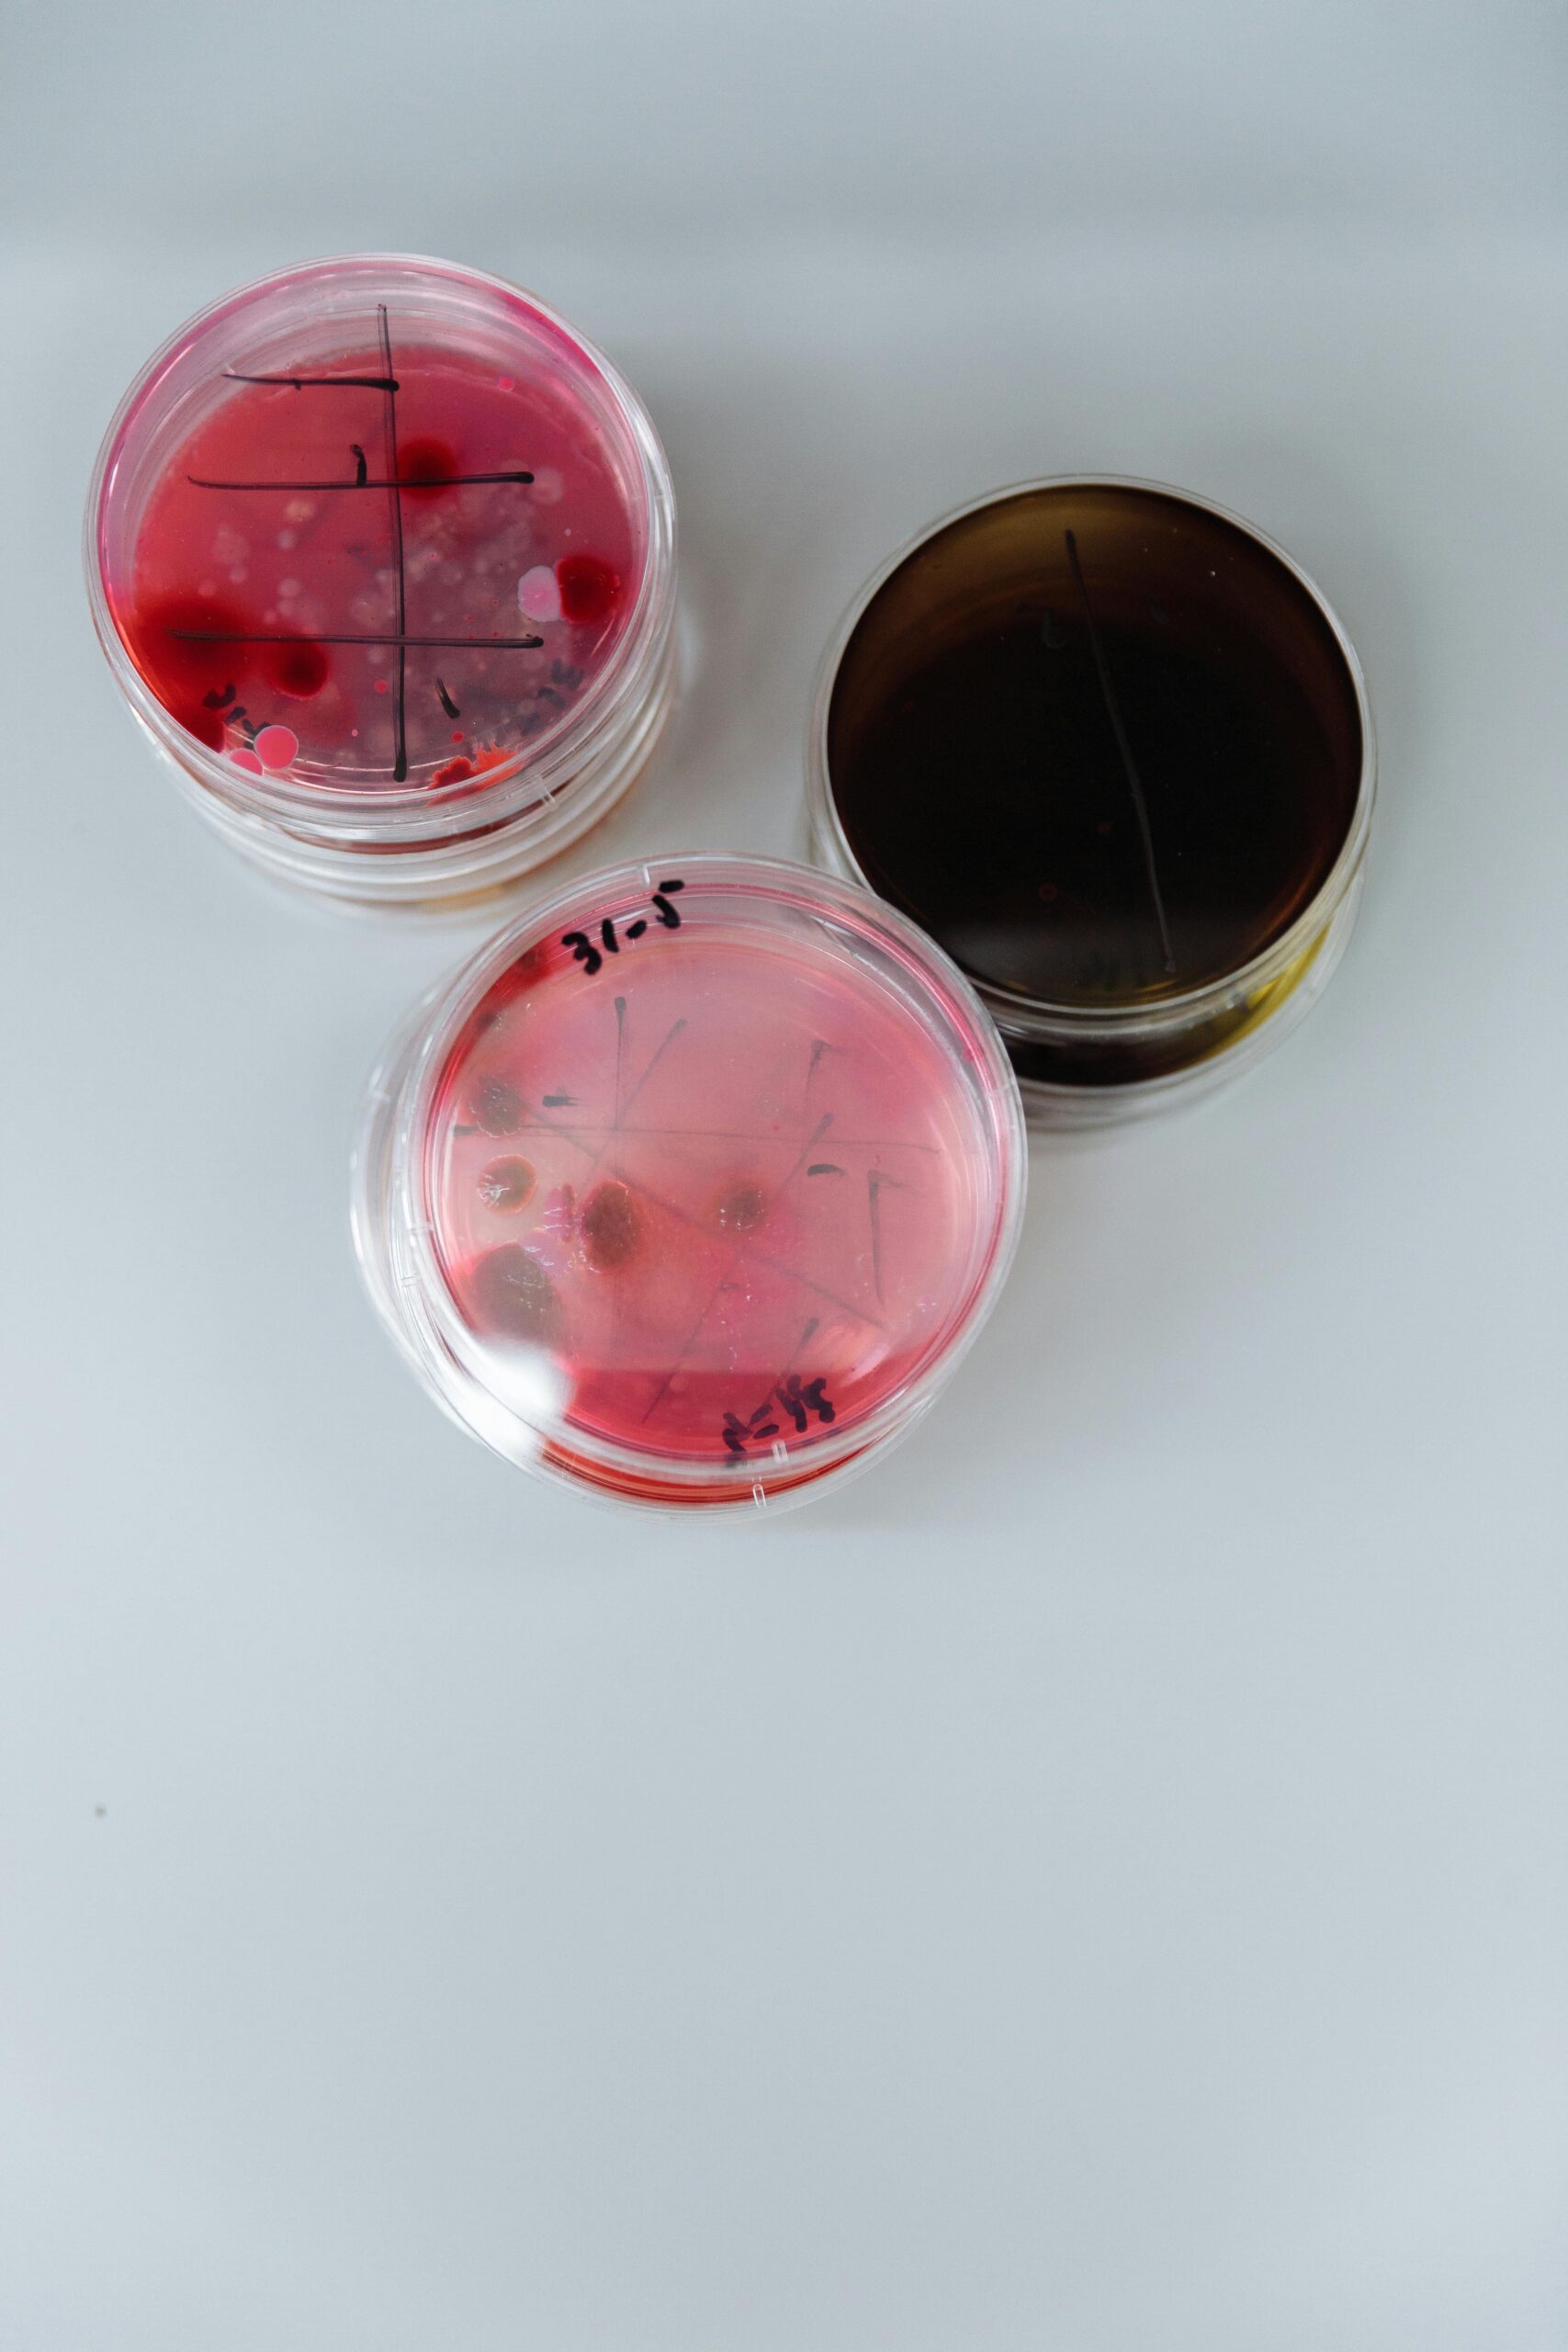

A finales del año pasado (Diciembre de 2023) se publicó el informe de la EFSA Persistencia de peligros microbiológicos en los entornos de producción y procesamiento de alimentos y piensos.
La Autoridad Europea de Seguridad Alimentaria (EFSA) solicitó al Panel de Peligros Biológicos (BIOHAZ) que emitiera una opinión científica sobre la persistencia de peligros microbiológicos en los entornos de producción y procesamiento de alimentos y piensos (FFPE: Food and Feed Processing Environment), excluida la producción primaria.
La «persistencia» microbiana se definió como la capacidad de un organismo determinado de establecerse en nichos (o sitios de refugio) dentro de la FFPE durante un largo plazo, a pesar de la aplicación frecuente de limpieza y desinfección (L&D). Requiere una existencia prolongada (que abarca meses o años), generalmente con multiplicación del microorganismo en el FFPE específico.

Premisas:
- Los entornos de producción de piensos (FePE: Feed-producing environments) estaban restringidos a los entornos de las instalaciones que producían y procesaban piensos para animales productores de alimentos.
- Los entornos de producción de alimentos (FoPE: Food-producing environments) abarcan entornos en los que se producen o procesan industrialmente alimentos de origen animal o no animal a nivel poscosecha.
- Los sectores considerados fueron:
- piensos para la producción animal.
- carne (incluidos mataderos y plantas procesadoras).
- pescado y marisco.
- lácteos.
- huevos y ovoproductos.
- frutas y verduras (incluidas las hierbas).
- alimentos con bajo contenido de humedad (LMF; low moisture food).
El estudio se basó en las principales alertas declaradas en el RASFF (Sistema rápido de alertas europeo) entre inicios de 2010 a mediados de 2022.
Desarrollo de la investigación:
El primer paso de la investigación era que la EFSA debía identificar los peligros microbiológicos para la seguridad alimentaria más relevantes asociados con la persistencia en el entorno de producción de estos sectores en la UE.
Con base en la definición de persistencia, se excluyeron:
- los virus y protozoos parásitos que, debido a su incapacidad para multiplicarse en superficies abióticas, no pueden establecerse a largo plazo ni constituir un reservorio de contaminación en los entornos de producción.
- las toxinas microbianas y otros metabolitos microbianos peligrosos.
Los peligros bacterianos más relevantes para la seguridad alimentaria se identificaron como:
- Salmonella enterica en el sector de producción animal de piensos para alimentación.
- Listeria monocytogenes y S. enterica en el sector cárnico.
- L. monocytogenes en el sector procesador de pescados y mariscos.
- L. monocytogenes en el sector lácteo.
- S. enterica en el sector de huevos y procesamiento de huevos;
- L. monocytogenes en el sector procesador de frutas y hortalizas.
- S. enterica y Cronobacter sakazakii en el sector LMF.
.
El segundo paso fue que la EFSA tenía que identificar los principales (sub)tipos de peligros más relevantes implicados en la persistencia y las principales características responsables de su persistencia en el entorno productivo.
Se concluyó que existe una amplia gama de subtipos que están involucrados en la persistencia en dichos entornos productivos para los tres peligros más relevantes enumerados anteriormente.
.
Algunos subtipos específicos se informan más comúnmente como persistentes asociados a:
- Mayor robustez ambiental.
- Tolerancia a la desinfección.
- Formación de biopelículas.
.
.
En general no se han identificado marcadores o características universales para la persistencia.
La 3ª fase del estudio fue que la EFSA identificara los factores de riesgo, es decir, aquellos factores a nivel de instalación que aumentan la probabilidad de persistencia de los peligros para la seguridad alimentaria en el entorno.
El principal factor de riesgo de los tres peligros bacterianos enumerados anteriormente en el entorno productivo es el diseño higiénico deficiente de los equipos y máquinas.
Esto conduce a nichos (o sitios de refugio) que son difíciles de limpiar y desinfectar y donde se pueden acumular restos de comida y humedad, y los peligros pueden sobrevivir y persistir.
Otros factores importantes son:
- zonificación y barreras higiénicas inadecuadas, que permiten la propagación de la contaminación de áreas contaminadas a áreas limpias.
- L&D inadecuada de las instalaciones.
- introducción de peligros a través de las materias primas, que pueden conducir a la colonización y propagación de clones persistentes en el entorno de procesamiento.
- humedad, que favorece la persistencia.
.
Específicamente para los peligros relevantes en ambientes de procesamiento seco, los factores de riesgo adicionales son:
- la transmisión aérea a través del polvo.
- el uso limitado de desinfectantes debido a las operaciones de limpieza en seco.
- la presencia de agua en el entorno, ya sea por limpieza en húmedo, condensación generada. a través de gradientes de temperatura dentro de la instalación o dentro del equipo, u otras fuentes.

.
Como etapa 4, la EFSA evaluó las medidas o intervenciones disponibles y mejoradas para monitorear, prevenir y/o controlar la persistencia de los peligros microbiológicos más relevantes para la seguridad alimentaria en los entornos productivos.
Se concluyó que un programa de pruebas y muestreo ambiental bien diseñado, siguiendo un enfoque basado en el riesgo, es la estrategia más eficaz para identificar fuentes de contaminación y detectar peligros potencialmente persistentes.
El establecimiento de barreras y medidas higiénicas dentro de los sistemas de gestión de seguridad alimentaria (FSMS: Food Safety Management System), durante la implementación del análisis de peligros y puntos críticos de control (APPCC), es clave para prevenir y/o controlar la persistencia bacteriana en el entorno evitando la entrada del peligro(s) a la planta de procesamiento y/o su distribución por la instalación.
Son de especial importancia los siguientes requisitos previos:
- infraestructura (edificio, equipamiento).
- obras que se acometan en las zonas de producción.
- acciones de mantenimiento y calibración.
- control de agua y aire.
- personal (higiene, estado de salud)
- operaciones de producción.
- cultura de seguridad alimentaria.
.
La confirmación de la presencia de una cepa persistente y la identificación de su nicho dentro de la instalación requiere la caracterización detallada de los aislamientos del peligro específico recuperados de muestras positivas utilizando métodos de subtipificación con suficiente resolución, preferiblemente secuenciación del genoma completo (WGS: Whole Genome Sequencing).
Una vez que se sospecha persistencia en una planta, con frecuencia se recomienda un enfoque de «buscar y destruir», que incluye:
- monitoreo intensificado.
- introducción de medidas para controlar el peligro.
- continuación del programa de monitoreo intensificado para confirmar la eficacia de las medidas tomadas o para identificar la necesidad de medidas adicionales.
.
Alternativamente, se pueden aplicar “análisis de causa raíz” sistemáticos para identificar los factores/sitios más probables dentro de las instalaciones que contribuyen al problema y definir las intervenciones más apropiadas para eliminar el patógeno de las instalaciones.
Se identificaron acciones exitosas desencadenadas por la persistencia de L. monocytogenes en el entorno de trabajo como:
- introducción de operaciones de limpieza y desinfección nuevas o especializadas (profundas).
- implementación de nuevos flujos de trabajo.
- instalación de nuevo sistema de drenaje.
- implementación de cambios y renovaciones estructurales.
- control de la contaminación de las materias primas y la mejora de la compartimentación.
- implementación simultánea de diversas acciones correctoras.
.
Además, se describen algunas otras opciones de intervenciones para eliminar los peligros persistentes con actividad bactericida directa y de diferente naturaleza, pero o no están disponibles comercialmente o su eficacia no está completamente validada en condiciones industriales como, por ejemplo:
- algunos químicos (por ejemplo, biocidas).
- nuevos métodos físicos (por ejemplo, calor o nuevas tecnologías no térmicas)
- medios biológicos (por ejemplo, fagos).
.
En la 5ª fase la EFSA debía identificar las lagunas de conocimiento y las prioridades para futuras investigaciones y desarrollar las perspectivas (u oportunidades futuras) de integrar la información recopilada en los estudios de fases anteriores.
Se proporcionan perspectivas para el uso de la evaluación de riesgos para combinaciones relevantes de peligro y producto alimenticio para evaluar los riesgos relativos que pueden asociarse con la persistencia, basándose en enfoques ascendentes (o hacia adelante) y de arriba hacia abajo (o hacia atrás).
Sin embargo, la dinámica de la persistencia y su papel en el riesgo será muy específica del proceso alimentario, y el modelo propuesto puede ser demasiado simple para capturar procesos biológicos importantes, como la formación de biopelículas.
Con los datos disponibles actualmente, la evaluación de riesgos de arriba hacia abajo no se puede utilizar para evaluar el riesgo relativo que puede atribuirse a la persistencia.
La evaluación de riesgos no puede aprovechar plenamente los datos recopilados para respaldar la respuesta a las preguntas frecuentes anteriores, y las necesidades de datos para la evaluación de riesgos no están bien cubiertas. La aplicación de estos datos requeriría una mejor traducción de la información genotípica de las cepas en características fenotípicas que puedan convertirse en parámetros de modelos de evaluación de riesgos, así como datos cuantitativos extensos para describir la dinámica de transferencia, supervivencia y crecimiento de las bacterias en el entorno.
Se han identificado nueve lagunas de conocimiento específicas y se han traducido en recomendaciones para la investigación.
La mayoría de las recomendaciones implicarían actividades en entornos industriales, pero algunas de las actividades de investigación podrían realizarse utilizando sistemas modelo de tipo industrial de ciertos nichos, donde se pueden probar diferentes cepas, condiciones ambientales e intervenciones potenciales.
Estas actividades de investigación permitirían establecer la contribución de marcadores genéticos específicos y su vínculo con los fenotipos asociados con la persistencia, y monitorear el impacto de intervenciones particulares para reducir o prevenir la persistencia.
También permitirían la generación de datos cuantitativos para describir la dinámica de transferencia, supervivencia y crecimiento de los peligros bacterianos y definir parámetros específicos de cepa o subtipo.
Se recomienda aplicar definiciones claras de persistencia en todas las áreas de investigación involucradas (observacional, experimental, epidemiológica, etc.) con el objetivo de lograr la misma definición inequívoca para todas ellas.
El programa de pruebas y muestreo ambiental debe ser sólido y estar cuidadosamente planificado por los operadores de empresas alimentarias y garantizar una vigilancia adecuada de los nichos de mayor riesgo para los peligros bacterianos objetivo y, durante la investigación de brotes, la estrategia de muestreo debe optimizarse y la presentación de datos a las autoridades oficiales. y se mejoró el muestreo industrial, con el fin de fortalecer el vínculo entre el entorno y los casos de brote.
También se recomienda promover el uso de estándares interoperables para recopilar y reportar metadatos asociados a los datos de secuenciación genómica para garantizar la auditabilidad, agilizar el intercambio de datos y reducir la incertidumbre.
Finalmente, se recomienda promover el acceso abierto tanto a los datos genómicos como a los metadatos asociados completos e inequívocos relacionados con el aislamiento de la cepa, respetando la confidencialidad de los datos y los intereses de los diferentes socios de la cadena alimentaria para investigar la persistencia en los entornos productivos.